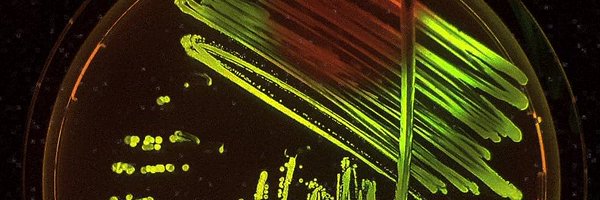
icvaraA Profile Banner

Içvara
@icvaraA
Followers
164
Following
2K
Media
2
Statuses
521
Today in @ScienceMagazine, we report a new DNA editing technology to seamlessly write massive changes into the right place in the human genome. The reason gene editing hasn't transformed human health is that current gene editing technologies like CRISPR are very limited. The
What if we could universally recombine, insert, delete, or invert any two pieces of DNA? In back-to-back @Nature papers, we report the discovery of bridge RNAs and 3 atomic structures of the first natural RNA-guided recombinase - a new mechanism for programmable genome design
75
676
3K
Finally, we can show you our project ! From brainstorming to benchwork, our iGEM adventure is on! 🚀 Watch our promo video and join the journey 💡🧪 #igem2025 #promotionalvideo #igemunil #syntheticbiology
0
1
1
A discovery platform for identification of host-induced bacterial biosensors from diverse sources https://t.co/CBTALBoHzy
0
2
30
Excited to announce that my work from @YSchaerli lab on phagemid based intercellular communication for distributed biocomputing in E. coli is now published! https://t.co/O4G2Z7oXwx
nature.com
Nature Communications - Engineering multicellular consortia, where information processing is distributed across specialized cell types, offers a promising strategy for implementing sophisticated...
2
7
27
Building material made of living fungus can repair itself for over a month. https://t.co/tbZf77d8R9 Chelsea Heveran & colleagues @CellRepPhysSci
0
7
24
MIT engineers engineered bacteria to produce hyperspectral signals that can be detected as far as 90 meters away. Their work could lead to the development of ba… Source: MIT News | Massachusetts Institute of Technology Shared via the Google app
news.mit.edu
MIT engineers engineered bacteria to produce hyperspectral signals that can be detected as far as 90 meters away. Their work could lead to the development of bacterial sensors for agricultural and...
2
33
139
🧬🤖 We've been featured in the European Biotechnology magazine in an article exploring the intersection of #AI and #SyntheticBiology! 👇 Want to read the full issue? Check it out here! https://t.co/RcrX7czTXc
0
4
7
Big congrats to Dr Lucas Coppens who successfully defended his PHD yesterday! Thanks to @chofski and Jose Jimenez, the fantastic examiners! Stay tuned for what is coming next 🚀
3
2
40
Need to design gram-positive bacteria? Our comprehensive genetic toolkit, SubtiToolKit (STK), can be really useful! Check out our study with @JCaroAstorga1 and @ProfTomEllis published in @TrendsinBiotech. STK is coming soon to @Addgene! #SynBio #Biotech 👇 https://t.co/5uwWlSwlLs
3
16
77
🌸 Spring is around the corner, and so is a colorful edition of our #newsletter, being released on Monday March 10th! This month’s theme will be #colours & #dyes and their applications #SyntheticBiology! 👉 Sign up now to get it straight to your inbox! https://t.co/UqZWWay2Zj
eusynbios.org
0
4
5
👋 I am a group leader @ Leeds, focused on the study and engineering of translation control in bacteria. Our interests span 🦠 Synthetic biology 🧬 Protein synthesis 🎨 Fluorescence 🧮 Quantitative biology and 📈 Data analysis. Lots going on over the next few weeks, stay tuned!
3
19
115
Here is a video of our @SKINDEV project if you want to know more of what we are cooking in the background 😉 https://t.co/Pp7q3QZiu1
1
1
3
C. acnes is the most abundant bacterium on human skin. But what if we could make it the smarterst? 🦠✨ In our new @cellsystems study, we programmed C. acnes to actively protect the skin for therapeutic applications! 🛡️ https://t.co/hb9JjqXyMs
3
11
42
🚨 Join us as an Instagram Content Creator! Passionate about #SyntheticBiology and/or #ScienceCommunication? Join us to help grow our online community! Interested? 👇 Check our website for full details and how to apply! https://t.co/WIEDQCIYMI
0
1
2
This is a really fun paper. The authors build a mathematical model to explain how the tulip breaking virus, or TBV, creates a stripe pattern on tulip petals. The writing is elegant, and the paper combines history, mathematics, and lots of other good stuff. Recommend.
9
140
798
China's Deep Seek is as good as ChatGPT o1. Plus, it's open source and free to use. Here are eight ways you can use Deep Seek for academic purposes:
29
310
1K
🍴If we are to feed the world, we need innovative, expert-led solutions, and soon! Today we’re launching the Bezos Centre for Sustainable Proteins to tackle our unsustainable and environmentally damaging food ecosystems. Find out more ⬇️ #BezosCentreImperial | @BezosCentre
2
13
53
Worth a look to see where synthetic and engineering needs to go for the UK. Excellent work by the committee. Let’s hope people making decisions are listening. 🤞
Today, the House of Lords Science and Technology Committee has published its report into engineering biology, entitled: “Don’t fail to scale: seizing the opportunity of engineering biology”. Read it here: https://t.co/iPz4NTniB6 and watch our Chair discuss 1/
0
5
17